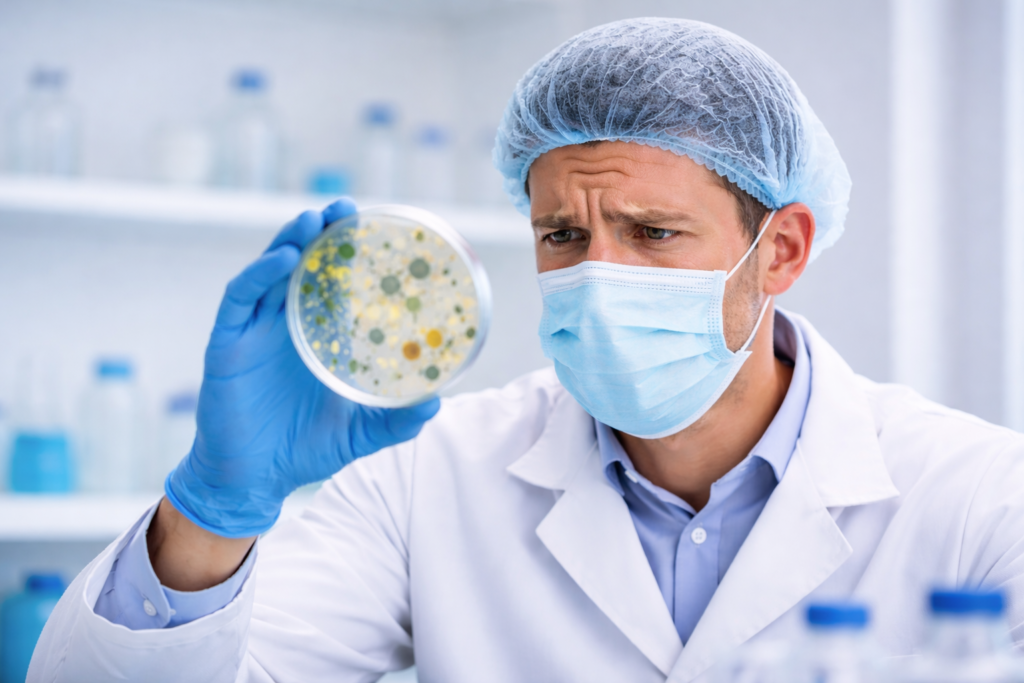

A single mistake in microbiological testing can compromise an entire batch. Analysts test raw materials, monitor cleanroom environments, verify sterility, and confirm that microbial contamination remains under control throughout manufacturing. Even small mistakes in microbiological procedures can lead to misleading results.
Because microbiological testing involves living organisms, environmental exposure, and strict aseptic techniques, the probability of deviations remains higher than in many other laboratory functions.
Regulatory agencies expect pharmaceutical companies to maintain robust microbiological monitoring systems and to emphasize microbiological control during inspections.
In real-world pharmaceutical laboratories, microbiology deviations usually develop from a combination of operator technique, environmental conditions, equipment performance, and procedural gaps.
Understanding the most common microbiology deviations helps laboratories detect problems earlier and implement stronger corrective actions.
1. Positive Results in Negative Controls
Negative controls play a critical role in microbiological testing. They confirm that the testing environment, culture media, and analytical procedures remain free from contamination. When microbial growth appears in a negative control, the reliability of the entire test becomes questionable.
This deviation often occurs during microbial limit testing, sterility testing, and environmental monitoring.
The most common causes include:
- Improper media preparation and sterilization
- Accidental contamination during testing
- Poor aseptic technique
- Improper environmental conditions
- Contaminated laboratory surfaces
These can easily introduce microorganisms into the controls.
When this deviation occurs, the investigation should begin with a review of the sterilization records, the analyst’s technique, and environmental monitoring data from the testing area. Supervisors should examine the laboratory cleaning records and verify whether the laminar airflow cabinets are operated within qualified conditions. Microbial identification also helps determine the source of contamination. If the organism matches common environmental flora or skin microorganisms, the contamination likely occurred during handling.
Corrective actions usually focus on improving aseptic technique, reinforcing cleaning practices, and retraining laboratory personnel.
2. Use of Expired Culture Media
Expired microbiological media cannot guarantee reliable microbial growth. This deviation still appears in many laboratories due to poor inventory control.
Yes, analysts sometimes use expired media unknowingly when labels fade or stock management fails.
In real laboratories, this deviation often happens because of weak inventory management and poor labeling practices. Analysts may overlook expiry labels or store media in crowded refrigerators where visibility becomes poor. Sometimes laboratories maintain excess stock, which increases the chance that media will expire before use.
The investigation should determine whether the expired media affected any microbiological test results. The laboratory must review testing records, identify the batches where the media was used, and evaluate whether the results remain valid.
To prevent recurrence, laboratories should implement strong inventory control systems. Clear labeling, first-expiry-first-out storage practices, and routine stock audits help maintain control over culture media usage.
3. Data Integrity Issues in Microbiology Records
Accurate documentation forms the foundation of a reliable pharmaceutical quality system.
Microbiology laboratories generate large volumes of data, including incubation records, colony counts, microbial identifications, and environmental monitoring results. Any inconsistency in these records raises concerns about data integrity.
Data integrity deviations may include overwritten entries, missing raw data, undocumented corrections, or incomplete test records. These issues often arise when analysts rush to complete documentation or when laboratories lack proper review systems.
Regulatory agencies emphasize strong data integrity practices.
During investigation, quality teams should examine laboratory notebooks, electronic data systems, and audit trails. They must determine whether the issue occurred due to human error, training gaps, or system limitations.
Corrective actions should include strengthening documentation practices, supervisory review procedures, and providing training on data integrity principles.
Read the following recommended articles to understand better:
- Real-World Documentation Errors in Pharma
- ALCOA Principles in Pharmaceuticals
- 10 Habits That Prevent Errors in Documentation in Pharma
- Pharmaceutical Documentation: Documented But Not Performed
- What Kind of Entry Errors Are Acceptable in Pharma Documentation?
- Common Documentation Errors in the Pharmaceutical Industry
4. Incorrect Sample Handling
Even if laboratory procedures remain perfect, improper sample collection or transport can compromise the entire analysis.
Incorrect sample handling may include
- Delays between sampling and testing
- Exposure of samples to non-controlled environments
- Improper storage temperatures
These mistakes can alter microbial populations within the sample and produce misleading results.
Investigators should review the complete sample journey from the production area to the microbiology laboratory. They should examine transport containers, holding times, and storage conditions. Training records of personnel involved in sampling should also be evaluated.
Clear sampling procedures, proper labeling systems, and defined sample transport timelines can significantly reduce this deviation.
5. Failure to Follow SOPs
Analysts sometimes skip minor steps because they appear routine or unnecessary. Over time, these shortcuts weaken process control and increase compliance risks.
Examples include:
- Skipping disinfection steps
- Altering incubation conditions
- Ignoring documentation requirements
- Using unapproved materials during testing
Investigations should determine whether the deviation occurred due to poor training, unclear SOP instructions, or workload pressure. Supervisors should review training records and interview the personnel involved.
Corrective actions often involve revising procedures for clarity, strengthening training programs, and reinforcing a culture of procedural compliance within the laboratory.
Microbiological deviations do not arise from complex technical failures. Most of them arise from everyday laboratory practices such as documentation, sample handling, material management, and adherence to procedures, and are mostly driven by human behavior. When laboratories identify these deviations early and investigate them thoroughly, they protect both product quality and regulatory compliance. A proactive microbiology team does not treat deviations as mere documentation requirements. Instead, it uses them as opportunities to improve laboratory systems, strengthen contamination control strategies, and build a more reliable quality culture.
